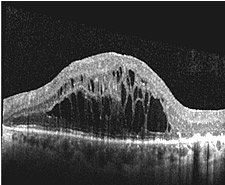
OCT-Bild der Makula eines Patienten mit Fl&uuml;ssigkeitserguss unter der Netzhaut

Diagnostik - Computer-Tomographie
 |
|
|||||||||
| OCT-Bild einer normalen Makula (Stelle des schärfsten Sehens der Netzhaut) mit typischer zentraler Einsenkung (Fovea) | OCT-Bild der Makula eines Patienten mit großen flüssigkeitsgefüllten Zysten im Bereich der Stelle des schärfsten Sehens der Netzhaut | |||||||||
Alle schwerwiegenden Erkrankungen des Augenhintergrundes gehen mit einer Strukturveränderung der mehrschichtigen Netzhaut oder des Sehnervens einher. Hierbei kann es in Abhängigkeit der Erkrankung beispielsweise zur Entstehung von Löchern in der Stelle des schärften Sehens (Makulaforamen), Zysten in der Netzhaut (diabetische Retinopathie), Wassereinlagerungen unter der Netzhaut (Makuladegeneration), Anschwellungen des Sehnerven (Durchblutungsstörungen) oder Aushöhlungen des Sehnerven (Glaukom) kommen. Eine den Patienten nicht belastende Untersuchung, mit der die Veränderungen von Netzhaut und Sehnerv dreidimensional sichtbar gemacht werden können, ist die optrische Computer-Tomographie, bei der mit einem niedrig-energetischen Laserstrahl der Augenhintergrund zeilenweise abgetastet und aus den reflektierten Lichtanteilen ein hochauflösendes Schichtbild gewonnen wird.
Beide Verfahren erlauben durch die hohe Bildauflösung und die digitale Bildspeicherung nicht nur eine exzellente Darstellung des Krankheitsprozesses sondern vor allem auch eine optimale Kontrolle nach durchgeführter Therapie und eine frühzeitige Erfassung von sich entwickelnden oder fortschreitenden Krankheitsprozessen. |
|
|||||||||




